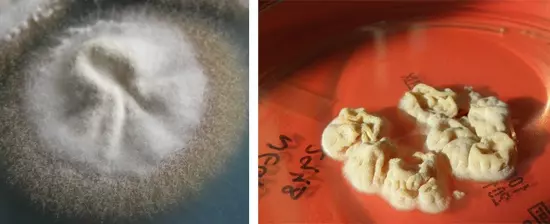
Паховая эпидермофития

Паховая эпидермофития – это инфекционное заболевания грибковой природы, вызываемое микроорганизмом из рода трихофитонов. Заболевание характеризуется поражением кожи в области естественных складок на теле человека – это паховые, ягодичные, подмышечные, складки под молочными железами.
Заболевание чаще регистрируется у лиц мужского пола, болеют в основном юноши и мужчины средних лет.
Видео:Паховая эпидермофитияСкачать

Причины возникновения паховой эпидермофитии
- снижение иммунитета:
- больные СПИДом;
- группа лиц, которая часто болеет острыми вирусными респираторными заболеваниями;
- больные сахарным диабетом, тиреотоксическим зобом, гипотиреозом;
- лица после недавно перенесенных оперативных вмешательств;
- беременность, послеродовой период;
- недостаток витаминов;
- онкологические больные;
- постоянные или частые нарушения целостности кожных покровов в местах, где паразитирует грибок (например, ношение неудобного нижнего белья);
- лица, которые задействованы на производствах с высокой температурой окружающей среды (мартеновские, доменные цеха);
- лица, проживающие на территориях с повышенной температурой и влажностью (Индия, страны Карибского бассейна);
- при несоблюдении личной гигиены (пользование общими полотенцами, мочалками).
Видео:Паховая эпидермофитияСкачать

Симптомы паховой эпидермофитии
- поражаются кожные покровы в естественных складках на теле человека – паховых, ягодичных, подмышечных, складки под грудью;
- очаги поражения представлены округлыми пятнами красного цвета с четко выраженной границей;
- очаги склоны к сливанию между собой;
- в центре пятна наблюдается шелушение, по периферии – обильное количество пузырьков с гнойным содержимым, которые лопаясь образуют на поверхности плотную темно-коричневую корку.
Видео:Лечение паховой эпидермофитии: противогрибковые средства, антимикотики. Народная медицинаСкачать

Диагностика паховой эпидермофитии
При возникновении вышеперечисленных симптомов необходимо обратится за квалифицированной медицинской помощью к врачу терапевту, семейному доктору, инфекционисту, дерматологу, гинекологу или урологу.
Диагноз устанавливается после проведения общего анализа крови, общего анализа мочи и мазка из очага поражения, который изучается под микроскопом.
Видео:Паховая эпидермофитияСкачать

Лечение паховой эпидермофитии
Местное лечение
- туалет очагов поражения – мытье под душем 2 раза в день используя детское мыло;
- очищение очага поражение от гнойных корок и чешуек – обработка перекисью водорода, салициловым спиртом или фукарцином;
- нанесение на очаги инфекции противогрибковых мазей и кремов:
- крем с кетоконазол наносится на пораженные участки кожи 2 раза в сутки. Курс лечения 4 – 5 недель;
- крем с клотримазол наносится на проблемные участки тела 2 раза в сутки. Длительность терапии составляет 3 – 5 недель;
- оксиконазол – крем наносят на очаги поражения 1 раз в сутки. Срок лечения 3 – 5 недель;
- мазь тербинафин – пораженную кожу обрабатывают 2 раз в сутки. Лечение продолжается до 3 – 5 недель;
- мазь нафтифин – кожа обрабатывается 2 раз в сутки. Курс лечения 3 – 4 недели.
Общее лечение
- флуконазол в таблетках назначается внутрь после приема пищи по 50—100 мг 2 раза в сутки. Прием препарата 7 — 14 дней;
- итраконазол в таблетках назначается после приема пищи внутрь, запивая небольшим количеством воды по 100—200 мг 2 раза в сутки в течение 7—10 дней;
- кетоконазол в таблетках для приема внутрь, назначается после еды по 200—400 мг 2 раза в сутки. Курс терапии 5 – 10 дней.
Видео:Паховая эпидермофития: причины, симптомы, диагностика, последствияСкачать

Паховая эпидермофития фото




🎬 Видео
Паховая эпидермофития. Как лечить паховую эпидермофитию.Скачать

Грибок. Паховая эпидермофития, лечение.Скачать

274 Паховая эпидермофития у женщин и мужчинСкачать

😕 Краснота и зуд паховой складки. Клинический случай №933Скачать

грибок в паху лечение дешево и легко | не нужны препараты и мазьСкачать

Паховая эпидермофития © EpidermophytosisСкачать

Красные пятна и шелушение на коже лобка и паха. Грибок паховой области.Скачать

Грибок в паху лечениеСкачать

1278 ЭпидермофитияСкачать

Грибок на коже мошонкиСкачать

Грибок в паху-как лечить?Скачать

Паховый грибок (грибок в паху)Скачать

Грибок кожи. Грибок в паху. Грибок на теле.Скачать

Дерматит в паху. Клинический случай №114Скачать